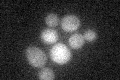
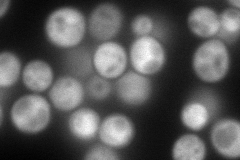
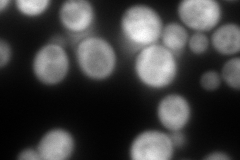
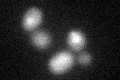
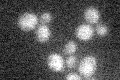

View description
Purine nucleoside phosphorylase, specifically metabolizes inosine and guanosine nucleosides; involved in the nicotinamide riboside salvage pathway
Localization:
Intensity:
Fold change:
Significance:
-
C’ GFP library in SD
below threshold17.84 -
N' NOP1pr-GFP in SD
cytosol190.993 -
N' TEF2pr-mCherry in SD
cytosol339.583 -
N' NATIVEpr-GFP in SD

cytosol43.1933 -
N' TEF2pr-VC and Cyto-VN in SD

cytosol60.7326 -
C’ GFP library in SD+DTT
cytosol20.91.17No -
C’ GFP library in SD+H2O2

cytosol19.171.07No -
C’ GFP library in Starvation Media
cytosol17.780.99No -
C’ GFP library on the background of Pup2-DaMP

below threshold -
C’ GFP library on the background of CCT mutant

below threshold22.47241.25902No
